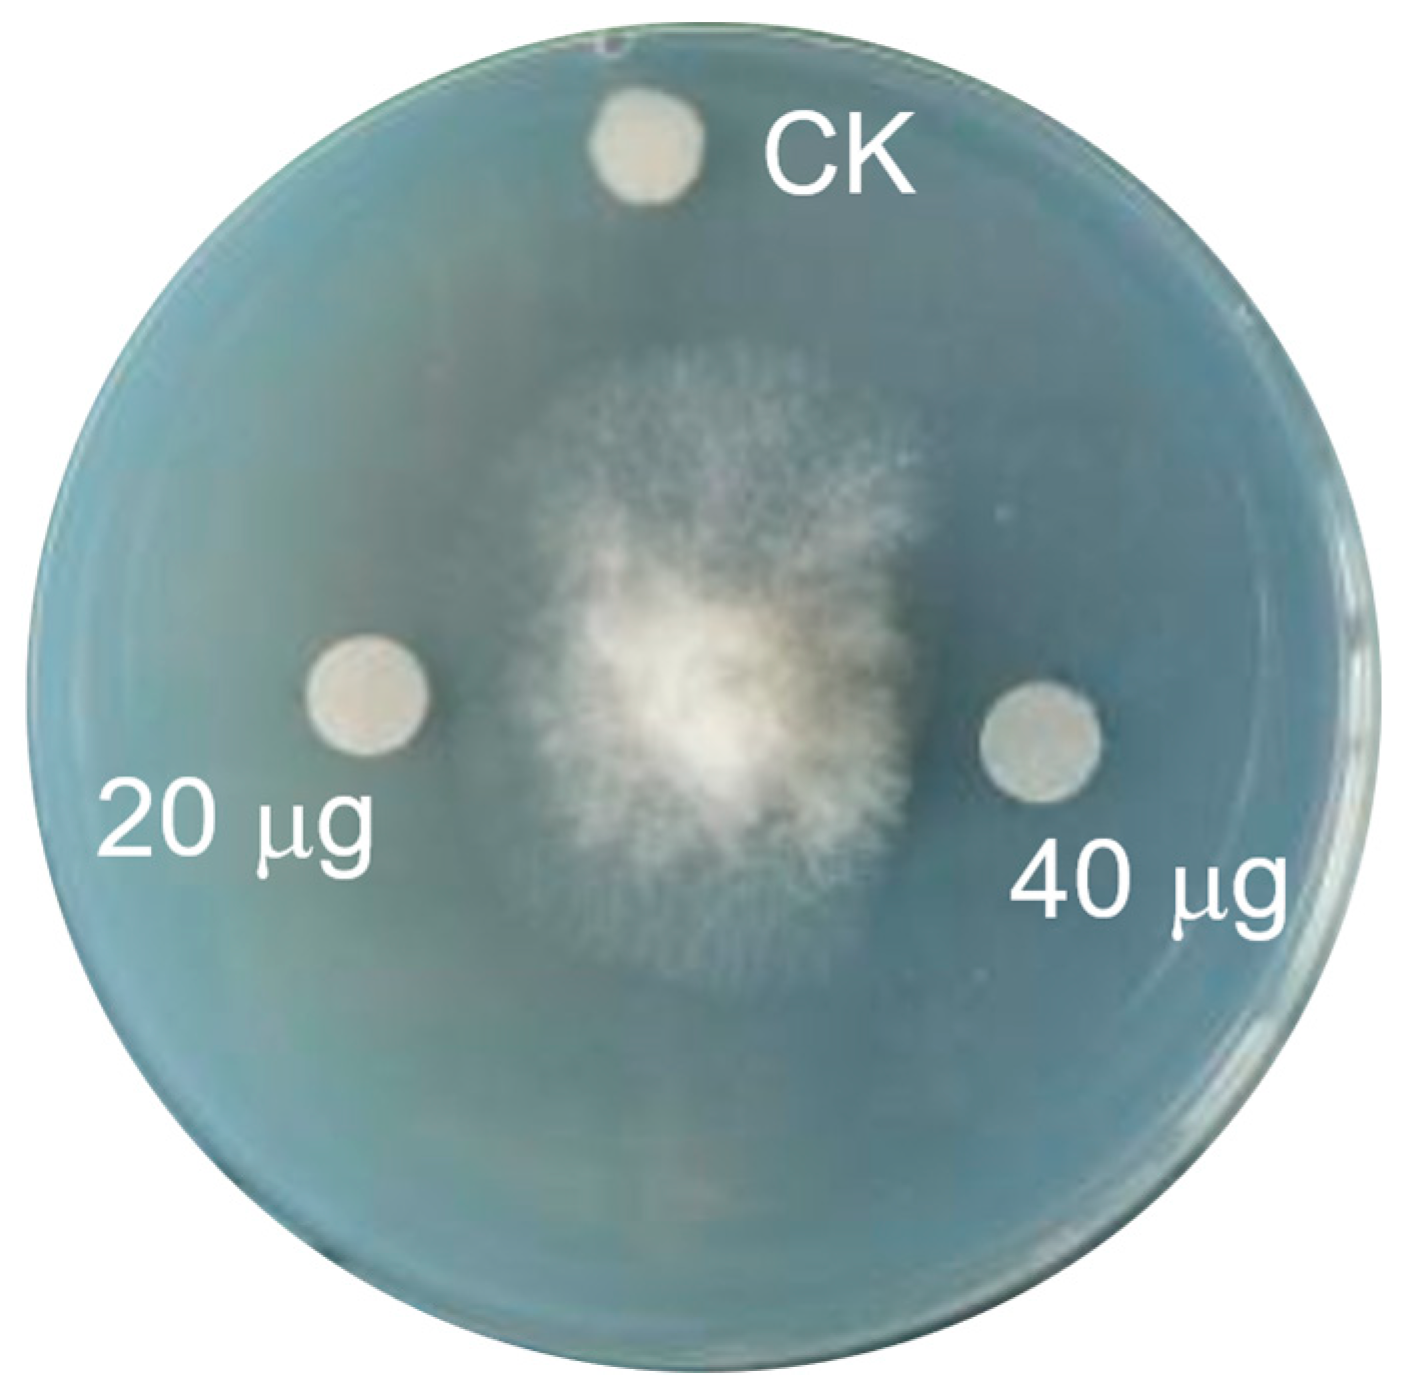
Molecules 28 07672 g007

Phenopyrrolizins A and B, Two Novel Pyrrolizine Alkaloids from Marine-Derived Actinomycetes Micromonospora sp. HU138
Abstract
:1. Introduction
2. Results
2.1. Identification of Strain
2.2. Structural Elucidation of Compounds 1 and 2
2.3. Bioactivity of Compounds 1 and 2
3. Materials and Methods
3.1. General Experimental Procedures
3.2. Strain Isolation and Identification
3.3. Fermentation, Extraction, and Isolation
- Phenopyrrolizin A (1): colorless prism; [α 0 (c 0.10, EtOH); UV (EtOH) λmax 366 (log ε 3.53), 268 (log ε 4.06) nm; IR (KBr): vmax 3281, 1599, 1532, 1475, 1236, 1150, 1085, 838 cm−1; 1H NMR (DMSO-d6, 400 MHz) and 13C NMR (DMSO-d6, 100 MHz) data see Table 1; HRESIMS m/z 246.1124 ([M + H]+, calculated for C14H16NO3 246.1125).
- Phenopyrrolizin B (2): colorless powder; [α 0 (c 0.10, EtOH); UV (EtOH) λmax 358 (log ε 3.77), 273 (log ε 4.21) nm; IR (KBr): vmax 3231, 1614, 1590, 1536, 1480, 1143, 1098, 897 cm−1; 1H NMR (DMSO-d6, 400 MHz) and 13C NMR (DMSO-d6, 100 MHz) data see Table 1; HRESIMS m/z 230.1181 ([M + H]+, calculated for C14H16NO2, 230.1176).
3.4. Crystallographic Data for 1
3.5. Bioactivity Assay
4. Conclusions
Supplementary Materials
Author Contributions
Funding
Institutional Review Board Statement
Informed Consent Statement
Data Availability Statement
Acknowledgments
Conflicts of Interest
References
- Yan, S.Q.; Zeng, M.Y.; Wang, H.; Zhang, H.W. Micromonospora: A prolific source of bioactive secondary metabolites with therapeutic potential. J. Med. Chem. 2022, 65, 8735–8771. [Google Scholar] [CrossRef]
- Breiner-Goldstein, E.; Eyal, Z.; Matzov, D.; Halfon, Y.; Cimicata, G.; Baum, M.; Rokney, A.; Ezernitchi, A.V.; Lowell, A.N.; Schmidt, J.J.; et al. Ribosome-binding and antimicrobial studies of the mycinamicins, 16-membered macrolide antibiotics from Micromonospora griseorubida. Nucleic Acids Res. 2021, 49, 9560–9573. [Google Scholar] [CrossRef] [PubMed]
- Gong, T.; Zhen, X.; Li, X.L.; Chen, J.J.; Chen, T.J.; Yang, J.L.; Zhu, P. Tetrocarcin Q, a new spirotetronate with a unique glycosyl group from a marine-derived actinomycete Micromonospora carbonacea LS276. Mar. Drugs 2018, 16, 74. [Google Scholar] [CrossRef] [PubMed]
- Takeuchi, T.; Hatano, M.; Muramatsu, H.; Kubota, Y.; Sawa, R.; Igarashi, M. Micromonosporamide A with glutamine-dependent cytotoxicity from Micromonospora sp. MM609M-173N6: Isolation, stereochemical determination, and synthesis. Org. Lett. 2021, 23, 7981–7985. [Google Scholar] [CrossRef]
- Chen, L.; Zhao, W.; Jiang, H.L.; Zhou, J.; Chen, X.M.; Lian, Y.Y.; Jiang, H.; Lin, F. Rakicidins G-I, cyclic depsipeptides from marine Micromonospora chalcea FIM 02–523. Tetrahedron 2018, 74, 4151–4154. [Google Scholar] [CrossRef]
- Maehr, H.; Liu, C.M.; Hermann, T.; Prosser, B.L.T.; Smallheer, J.M.; Palleroni, N.J. Microbial products. IV. X-14847, a new aminoglycoside from Micromonospora echinospora. J. Antibiot. 1980, 33, 1431–1436. [Google Scholar] [CrossRef]
- Unwin, J.; Standage, S.; Alexander, D.; Hosted, T.; Horan, A.C.; Wellington, E.M.H. Gene cluster in Micromonospora echinospora ATCC15835 for the biosynthesis of the gentamicin C complex. J. Antibiot. 2004, 57, 436–445. [Google Scholar] [CrossRef]
- Zhou, Q.; Luo, G.C.; Zhang, H.Z.; Tang, G.L. Discovery of 16-demethylrifamycins by removing the predominant polyketide biosynthesis pathway in Micromonospora sp. strain TP-A0468. Appl. Environ. Microbiol. 2019, 85, e02597-18. [Google Scholar] [CrossRef]
- Williams, D.E.; Dalisay, D.S.; Chen, J.; Polishchuck, E.A.; Patrick, B.O.; Narula, G.; Ko, M.; Av-Gay, Y.; Li, H.; Magarvey, N.; et al. Aminorifamycins and sporalactams produced in culture by a Micromonospora sp. isolated from a Northeastern-Pacific marine sediment are potent antibiotics. Org. Lett. 2017, 19, 766–769. [Google Scholar] [CrossRef]
- Wang, J.X.; Li, W.; Wang, H.X.; Lu, C.H. Pentaketide ansamycin microansamycins A-I from Micromonospora sp. Reveal diverse post-PKS modifications. Org. Lett. 2018, 20, 1058–1061. [Google Scholar] [CrossRef]
- Sarmiento-Vizcaino, A.; Brana, A.F.; Perez-Victoria, I.; Martin, J.; de Pedro, N.; de la Cruz, M.; Diaz, C.; Vicente, F.; Acuna, J.L.; Reyes, F.; et al. Paulomycin G, a new natural product with cytotoxic activity against tumor cell lines produced by deep-sea sediment derived Micromonospora matsumotoense M-412 from the Aviles Canyon in the Cantabrian Sea. Mar. Drugs 2017, 15, 271. [Google Scholar] [CrossRef] [PubMed]
- Kawahara, T.; Itoh, M.; Izumikawa, M.; Kozone, I.; Sakata, N.; Tsuchida, T.; Shin-Ya, K. New hydroxamate metabolite, MBJ-0003, from Micromonospora sp. 29867. J. Antibiot. 2014, 67, 261–263. [Google Scholar] [CrossRef] [PubMed]
- Kopp, J.; Brueckner, R. Stereoselective total synthesis of the dimeric naphthoquinonopyrano-gamma-lactone (–)-crisamicin A: Introducing the dimerization site by a late-stage Hartwig borylation. Org. Lett. 2020, 22, 3607–3612. [Google Scholar] [CrossRef] [PubMed]
- Mullowney, M.; Ó hAinmhire, E.; Tanouye, U.; Burdette, J.; Pham, V.; Murphy, B. A pimarane diterpene and cytotoxic angucyclines from a marine-derived Micromonospora sp. in Vietnam’s East Sea. Mar. Drugs 2015, 13, 5815–5827. [Google Scholar] [CrossRef]
- Wang, Z.; Wen, Z.; Liu, L.; Zhu, X.; Shen, B.; Yan, X.; Duan, Y.; Huang, Y. Yangpumicins F and G, enediyne congeners from Micromonospora yangpuensis DSM 45577. J. Nat. Prod. 2019, 82, 2483–2488. [Google Scholar] [CrossRef]
- Chu, M.; Mierzwa, R.; Jenkins, J.; Chan, T.M.; Das, P.; Pramanik, B.; Patel, M.; Gullo, V. Isolation and characterization of novel oligosaccharides related to ziracin. J. Nat. Prod. 2002, 65, 1588–1593. [Google Scholar] [CrossRef]
- McCranie, E.K.; Bachmann, B.O. Bioactive oligosaccharide natural products. Nat. Prod. Rep. 2014, 31, 1026–1042. [Google Scholar] [CrossRef]
- Wang, R.J.; Zhang, S.Y.; Ye, Y.H.; Yu, Z.; Qi, H.; Zhang, H.; Xue, Z.L.; Wang, J.D.; Wu, M. Three new isoflavonoid glycosides from the mangrove-derived actinomycete Micromonospora aurantiaca 110B. Mar. Drugs 2019, 17, 294. [Google Scholar] [CrossRef]
- Zhang, Y.; Adnani, N.; Braun, D.R.; Ellis, G.A.; Barns, K.J.; Parker-Nance, S.; Guzei, I.A.; Bugni, T.S. Micromonohalimanes A and B: Antibacterial halimane-type diterpenoids from a marine Micromonospora species. J. Nat. Prod. 2016, 79, 2968–2972. [Google Scholar] [CrossRef]
- Chang, Y.Y.; Chai, B.Z.; Ding, Y.K.; He, M.; Zheng, L.H.; Teng, Y.; Deng, Z.X.; Yu, Y.; Liu, T.G. Overproduction of gentamicin B in industrial strain Micromonospora echinospora CCTCC M 2018898 by cloning of the missing genes genR and genS. Metab. Eng. Commun. 2019, 9, e00096. [Google Scholar] [CrossRef]
- Reimann, H.; Cooper, D.J.; Mallams, A.K.; Jaret, R.S.; Yehaskel, A.; Kugelman, M.; Vernay, H.F.; Schumacher, D. Structure of sisomicin, a novel unsaturated aminocyclitol antibiotic from Micromonospora inyoensis. J. Org. Chem. 1974, 39, 1451–1457. [Google Scholar] [CrossRef] [PubMed]
- Qi, S.S.; Gui, M.; Li, H.; Yu, C.B.; Li, H.J.; Zeng, Z.L.; Sun, P. Secondary metabolites from marine Micromonospora: Chemistry and bioactivities. Chem. Biodivers. 2020, 17, e2000024. [Google Scholar] [CrossRef] [PubMed]
- Fu, G.Y.; Wang, R.J.; Ding, J.L.; Qi, H.; Zhao, Z.; Chen, C.; Zhang, H.; Xue, Z.L.; Wang, J.D.; Wu, M. Micromonospora zhangzhouensis sp. nov., a novel actinobacterium isolated from mangrove soil, exerts a cytotoxic activity in vitro. Sci. Rep. 2020, 10, 3889. [Google Scholar] [CrossRef]
- Embley, T. The linear PCR reaction: A simple and robust method for sequencing amplified rRNA genes. Lett. Appl. Microbiol. 1991, 13, 171–174. [Google Scholar] [CrossRef]
- Thompson, J.D.; Higgins, D.G.; Gibson, T.J. CLUSTAL W: Improving the sensitivity of progressive multiple sequence alignment through sequence weighting, positions-specific gap penalties and weight matrix choice. Nucleic Acids Res. 1994, 22, 4673–4680. [Google Scholar] [CrossRef]
- Saitou, N.; Nei, M. The neighbour-joining method: A new method for reconstructing phylogenetic trees. Mol. Biol. Evol. 1987, 4, 406–425. [Google Scholar] [PubMed]
- Felsenstein, J. Confidence limits on phylogenies: An approach using the bootstrap. Evolution 1985, 39, 783–791. [Google Scholar] [CrossRef]
- Felsenstein, J. Evolutionary trees from DNA sequences: A maximum likelihood approach. J. Mol. Evol. 1981, 17, 368–376. [Google Scholar] [CrossRef]
- Kimura, M. A simple method for estimating evolutionary rates of base substitutions through comparative studies of nucleotide sequences. J. Mol. Evol. 1981, 16, 111–120. [Google Scholar] [CrossRef]
- Zhang, S.; Cai, J.; Xie, Y.; Zhang, X.; Yang, X.; Lin, S.; Xiang, W.; Zhang, J. Discovery of febrifugine with specific anti-oomycete activity isolated from Dichroa febrifuga Lour. Ind. Crops Prod. 2022, 178, 114651. [Google Scholar] [CrossRef]
- Zhang, S.; Wang, Y.; Cai, J.; Liu, D.; Yan, Y.; Zhang, H.; Li, L.; Wang, X.; Xiang, W.; Zhang, J. Anti-phytophthora activity of halofuginone and the corresponding mode of action. J. Agric. Food Chem. 2022, 70, 12364–12371. [Google Scholar] [CrossRef] [PubMed]
- Wang, J.D.; Zhang, H.; Yang, X.H.; Zhou, Y.; Wang, H.B.; Bai, H. HS071, a new furan-type cytotoxic metabolite from Streptomyces sp. HS-HY-071. J. Antibiot. 2008, 61, 623–626. [Google Scholar] [CrossRef] [PubMed]
- Gouda, A.; Abdelazeem, A.H. An integrated overview on pyrrolizines as potential anti-inflammatory, analgesic and antipyretic agents. Eur. J. Med. Chem. 2016, 114, 257–292. [Google Scholar] [CrossRef]
- Schimming, O.; Challinor, V.L.; Tobias, N.J.; Adihou, H.; Grün, P.; Pöschel, L.; Richter, C.; Schwalbe, H.; Bode, H.B. Structure, biosynthesis, and occurrence of bacterial pyrrolizidine alkaloids. Angew. Chem. Int. Ed. Engl. 2015, 54, 12702–12705. [Google Scholar] [CrossRef] [PubMed]

| Position | 1 | 2 | ||
|---|---|---|---|---|
| δC | δH (J in Hz) | δC | δH (J in Hz) | |
| 1 | 85.7 s | / | 85.8 s | / |
| 2 | 199.8 s | / | 199.7 s | / |
| 3 | 100.8 s | / | 100.2 s | / |
| 4 | 179.0 s | / | 180.0 s | / |
| 5 | 29.0 t | 3.05 (m) | 29.4 t | 3.14 (m) |
| 6 | 23.1 t | 2.21 (m) | 23.1 t | 2.26 (m) |
| 7 | 42.9 t | 3.33 (m) | 43.0 t | 3.38 (m) |
| 3.42 (m) | 3.47 (m) | |||
| 8 | 21.5 q | 1.24 (m) | 21.5 q | 1.27 (m) |
| 9 | 125.1 s | / | 134.4 s | / |
| 10, 14 | 126.1 d | 7.45 (d, 8.6) | 124.6 d | 7.66 (d, 7.9) |
| 11, 13 | 115.4 d | 6.69 (d, 8.6) | 128.6 d | 7.26 (t, 7.9) |
| 12 | 154.4 s | / | 124.1 d | 7.02 (t, 7.9) |
| 1-OH | / | 6.26 (s) | / | 6.37 (s) |
| 12-OH | / | 9.09 (s) | / | / |
Disclaimer/Publisher’s Note: The statements, opinions and data contained in all publications are solely those of the individual author(s) and contributor(s) and not of MDPI and/or the editor(s). MDPI and/or the editor(s) disclaim responsibility for any injury to people or property resulting from any ideas, methods, instructions or products referred to in the content. |
© 2023 by the authors. Licensee MDPI, Basel, Switzerland. This article is an open access article distributed under the terms and conditions of the Creative Commons Attribution (CC BY) license (https://creativecommons.org/licenses/by/4.0/).
Share and Cite
Zhang, H.; Ren, X.; Xu, H.; Qi, H.; Du, S.; Huang, J.; Zhang, J.; Wang, J. Phenopyrrolizins A and B, Two Novel Pyrrolizine Alkaloids from Marine-Derived Actinomycetes Micromonospora sp. HU138. Molecules 2023, 28, 7672. https://doi.org/10.3390/molecules28227672
Zhang H, Ren X, Xu H, Qi H, Du S, Huang J, Zhang J, Wang J. Phenopyrrolizins A and B, Two Novel Pyrrolizine Alkaloids from Marine-Derived Actinomycetes Micromonospora sp. HU138. Molecules. 2023; 28(22):7672. https://doi.org/10.3390/molecules28227672
Chicago/Turabian StyleZhang, Hui, Xiaohan Ren, Haiju Xu, Huan Qi, Shihua Du, Jun Huang, Ji Zhang, and Jidong Wang. 2023. "Phenopyrrolizins A and B, Two Novel Pyrrolizine Alkaloids from Marine-Derived Actinomycetes Micromonospora sp. HU138" Molecules 28, no. 22: 7672. https://doi.org/10.3390/molecules28227672
APA StyleZhang, H., Ren, X., Xu, H., Qi, H., Du, S., Huang, J., Zhang, J., & Wang, J. (2023). Phenopyrrolizins A and B, Two Novel Pyrrolizine Alkaloids from Marine-Derived Actinomycetes Micromonospora sp. HU138. Molecules, 28(22), 7672. https://doi.org/10.3390/molecules28227672

